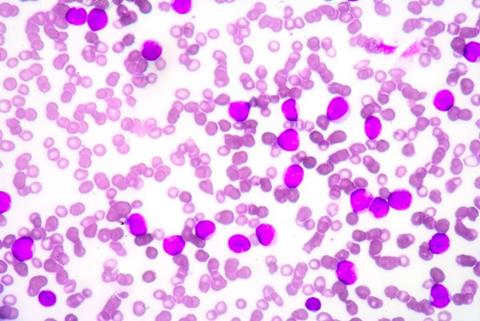
Image

The innovative protocol could improve stem cell transplants and make them safer, enabling a broader disease population to take advantage of the benefits.
New data from a Phase I clinical trial has demonstrated an innovative approach to reduce the toxicity of stem cell transplants in Fanconi anaemia patients. The antibody-based combination regimen did not use busulfan chemotherapy or radiation and showed “exceptional outcomes”, according to Dr Agnieszka Czechowicz, PhD, Assistant Professor of Paediatrics, Stanford Medicine.
The finding is significant because the genetic disease makes standard stem cell transplant is extremely risky, Agarwal et al. stated.
Addressing challenges in stem cell transplants with a novel antibody protocol
The three participants were under ten years old when they received their transplants.
While the researchers initially aimed for patients to receive one percent of bone marrow cells from a donor, a two-year follow up found that every patient had nearly 100 percent of their cells from their donors. “We’ve been surprised by how well it’s worked”, Dr Czechowicz reflected.
Participants took immune-suppressing medications before the stem cell transplant. Then, instead of radiation or busulfan chemotherapy, they received an intravenous anti-CD117 briquilimab antibody infusion 12 days prior to receiving the donated stem cells. This process eliminated blood-forming stem cells without toxic side effects.
Each patient had a stem cell transplant consisting of cells donated by a parent, depleted of alpha/beta T-cells and enriched for blood-forming stem cells.
Within a fortnight, the donated stem cells rapidly integrated into the patients’ bone marrow. Thirty days post-transplant, the healthy donor cells had nearly fully overtaken the bone marrow. There was no report of graft rejection.
Broadening the scope
“We are expanding the donors for stem cell transplantation in a major way, so every patient who needs a transplant can get one"
“Bone marrow or stem cell transplants are most commonly used in blood cancers… But as we’re making these transplants better and safer, we can expand them to more patients including those with many different diseases,” explained Dr Czechowicz.
“We are expanding the donors for stem cell transplantation in a major way, so every patient who needs a transplant can get one,” co-first author Dr Rajni Agarwal, Professor of Paediatric Stem Cell Transplantation noted.
She added that elderly cancer patients are at a disadvantage when it comes to tolerating full doses of radiation or chemotherapy. This new antibody protocol “may provide us with a way to treat them with less intensity so it’s possible for them to get a transplant.”
Looking ahead, the team also hope their new approach can reduce the high rates of Fanconi anaemia patients getting secondary cancers by 40 years old, which can result from their body’s condition.
An ongoing Phase II trial is evaluating the antibody treatment to improve stem cell transplants in additional children with Fanconi anaemia.
The findings were published in Nature Medicine.














